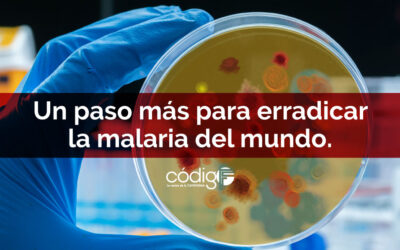
Un paso más para erradicar la malaria del mundo.

Continúa la búsqueda de medicamentos para el tratamiento efectivo de pacientes con COVID-19.
Varios equipos de investigación, entre los que se encuentran el dirigido por la Universidad de Birmingham y la Universidad de Keele en el Reino Unido y el Instituto Científico San Raffaele en Italia; el formado por MSD y Ridgeback Biotherapeutics; la dupla de Eli...
La OMS promueve el uso ético y respetuoso de la Inteligencia Artificial en el ámbito de la salud.
La IA podría ayudar a mejorar la salud de millones de personas en todo el mundo, pero su uso debe estar normado.Sin lugar a dudas, el uso racional de los recursos tecnológicos y de la inteligencia artificial (IA) han sido elementos decisivos para la consecución de...
Un paso más para erradicar la malaria del mundo.
El laboratorio Sanaria desarrolla dos vacunas con una eficacia contra la malaria nunca antes obtenida. Una de las enfermedades parasitarias más feroces, antiguas, y directamente responsable de cuando menos 409 mil muertes documentadas durante 2019, de las que...
La ciencia básica, la ciencia aplicada, y la transferencia de conocimientos.
“Recordemos la ciencia del pasado, fascinémonos con la ciencia del futuro pero, sobre todo, hagamos ver la presencia de la ciencia detrás de las pequeñas cosas”.José Manuel López Nicolás, investigador y catedrático de bioquímica, biología molecular y vicerrector de...
Se obtiene por primera vez la secuencia completa de un genoma humano.
Desde el borrador del 2001 no se había concluído dicho trabajo, ahora el Consorcio internacional Telomere to Telomere formado por más de 100 investigadores, lo ha terminado. La secuencia completa del genoma humano, el ordenamiento de ADN con las instrucciones...
El descubrimiento de un biomarcador, ofrece una alternativa simple para el diagnóstico de la miocarditis.
La enfermedad está subdiagnosticada, ya que se confunde fácilmente con un infarto al miocardio. La miocarditis, una seria afección cardíaca potencialmente mortal y cuyo desarrollo está generalmente relacionado con la presencia de patógenos infecciosos (virus,...